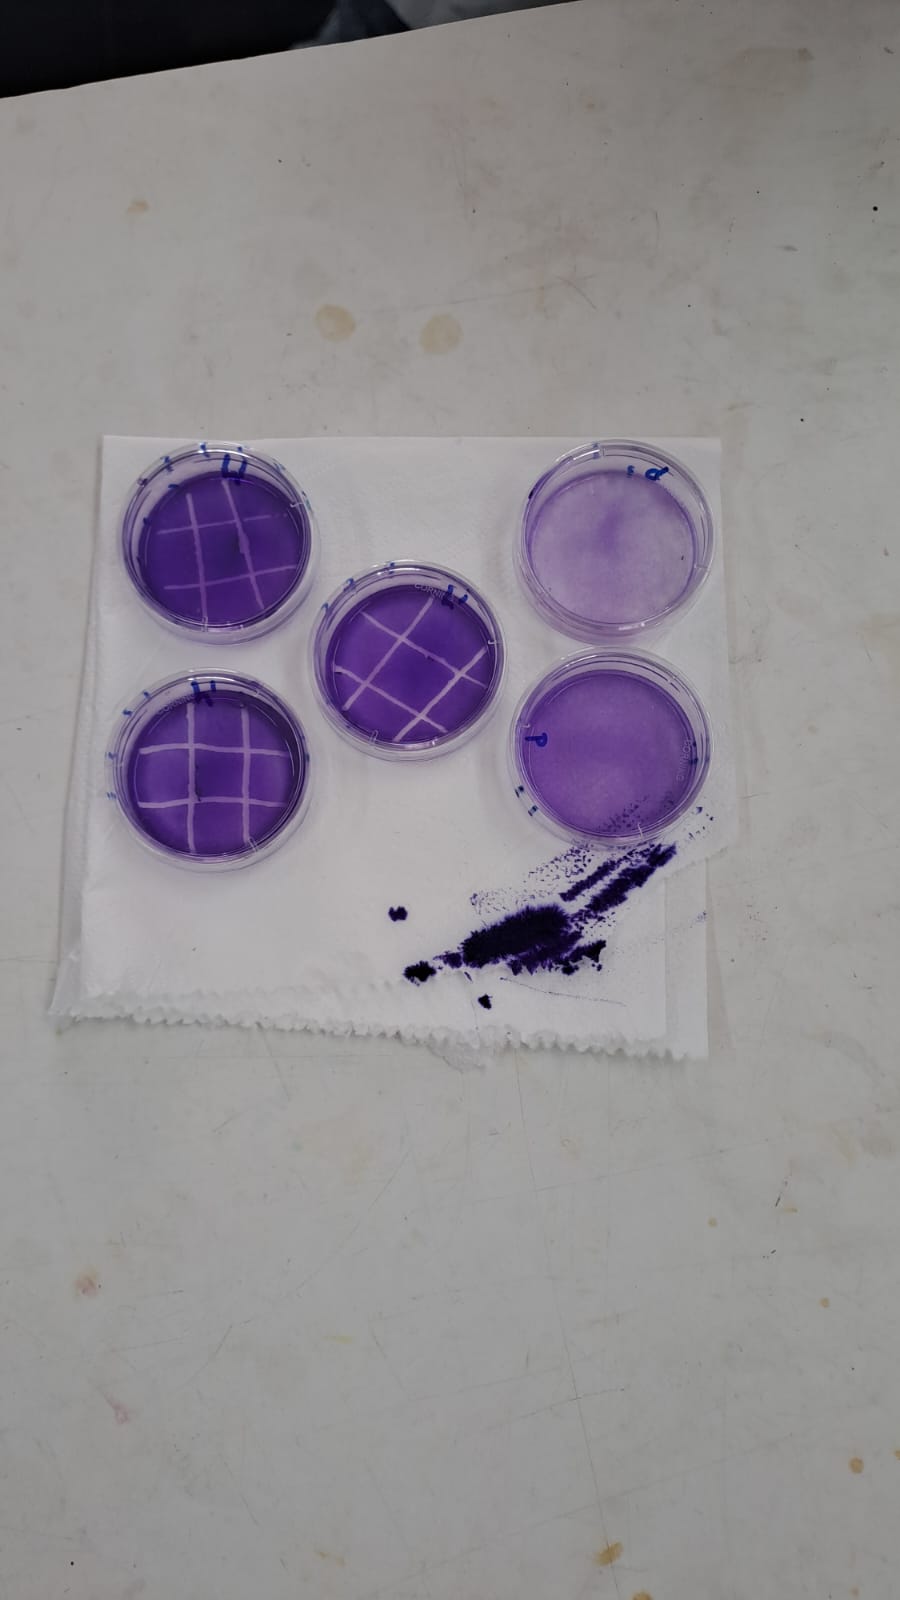

Materia Optativa para las Carreras de Farmacia, Bioquímica y de Biotecnología
Curso de Posgrado valido para el Doctorado
Clase Inaugural: Jueves 2 de Agosto 2025
Días de cursada: Jueves de 14 a 18hs
Modalidad: presencial.
Aula: 110 (1er piso edificio Abuelas Plaza de Mayo)
- Profesor: Juan Manuel Fernandez
- Profesor: Antonio Desmond Mc Carthy